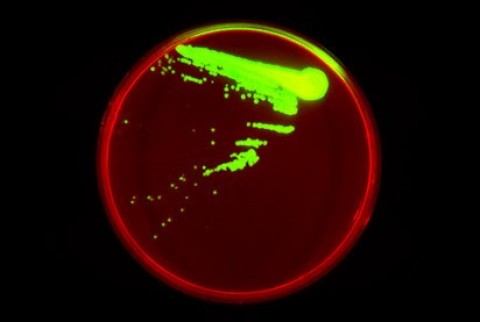
Imagem fluorescente do organismo semi-sintético de Synthorx.

Novo tipo de vida semi-sintética é criado
 Os blocos de construção do DNA foram expandidos por cientistas que criaram um organismo semi-sintético, o qual é estável e capaz de produzir compostos biológicos que nunca antes foram vistos.
Os blocos de construção do DNA foram expandidos por cientistas que criaram um organismo semi-sintético, o qual é estável e capaz de produzir compostos biológicos que nunca antes foram vistos.
O DNA compõe todas as coisas que vivem na Terra, e é composto por quatro nucleotídeos que são básicos. No entanto, a nova forma de vida que os pesquisadores desenvolveram nos Estados Unidos possui seis, e isso torna as coisas muito interessantes. O SSO, sigla para organismo semi-sintético em inglês, que foi projetado por uma equipe do Scripps Research Institute na Califórnia, foi formado a partir das quatro bases de núcleos normais, o mesmo que os humanos.
Imagem fluorescente do organismo semi-sintético de Synthorx.
Imagem fluorescente do organismo semi-sintético de Synthorx.
Estas são adenina, citosina, guanina e timina, mas também tem dois nucleotídeos que também não são naturais. Isso significa que recebe mais duas letras, X e Y nos pares de bases de DNA, que são essencialmente os degraus da escada que mantêm as espirais do DNA juntas.
Membros da equipe de pesquisa criaram o mesmo tipo de par de bases de DNA sintético em 2014, o que revelou que poderia ser incorporado na bactéria E. Coli que havia sido modificada. Isso levou à criação do primeiro organismo vivo com letras extras, e também deu lugar à expansão do código genético que poderia essencialmente permitir novos tipos de processos biológicos. No entanto, houve um problema com a estabilidade. O organismo semi-sintético conseguiu manter seus nucleotídeos não naturais, mas não conseguiu mantê-los quando as células estavam se dividindo indefinidamente.
CRISPR-Cas9 foi usado por pesquisadores
Floyd Romesberg, o principal investigador, disse que o genoma não é apenas estável por um dia; ele precisa ter estabilidade ao longo da escala de uma vida. Ele ainda disse que se o organismo semi-sintético fosse um organismo, então ele deve manter a informação em condições estáveis.
 O professor Floyd Romesberg (à direita) e o estudante de graduação Yorke Zhang lideraram o novo estudo no The Scripps Research Institute.
O professor Floyd Romesberg (à direita) e o estudante de graduação Yorke Zhang lideraram o novo estudo no The Scripps Research Institute.
Para contornar isso, os pesquisadores encontraram uma maneira para o organismo semi-sintético poder manter o par de bases X e Y que não eram naturais. Isto foi possível devido a um transportador de nucleotídeos. Os resultados disso foram revelados pela primeira vez em janeiro e foi o primeiro organismo estável usando o código genético de 6 letras.
Agora, um novo estudo foi publicado e os pesquisadores revelaram que mais melhorias desse tipo foram feitas para a estabilidade molecular, graças à bactéria semi-sintética que é capaz de transcrever e depois traduzir os nucleotídeos X e Y não naturais com exatamente a mesma eficiência como os nucleotídeos naturais, que são A, C, G e T.
Graças a um novo processo de transcrição, o organismo é capaz de sintetizar proteínas que contêm aminoácidos não canônicos e este é um processo que pode lançar nova luz sobre formas de replicação de moléculas com dependência menor em ligações de hidrogênio…
Os subprodutos são proteínas derivadas de primeira geração nunca vistas antes
Os cientistas revelaram que os subprodutos são a primeira de uma nova geração de proteínas derivadas que são semi-sintéticas e que nunca antes foram vistas na natureza, por terem incorporação estável e indefinida do par de bases não natural… Eles ainda disseram este é considerado somente o primeiro do novo tipo de vida semi-sintética que pode ter acesso a uma ampla gama de formas e funções, e que não estão disponíveis para organismos naturais. No momento, os pesquisadores não sabem aonde isso vai levar, no entanto, uma coisa é certa: a complexidade da vida na Terra deu um grande passo à frente.
Fonte: http://ovnihoje.com/2017/11/30/organismo-semi-sintetico-e-criado/
‘Meu Povo, a ciência mal empregue está a criar uma nova raça, ao lutar para superar-me ‘ABOMINAÇÃO’ é o que estas criaturas cometem contra o dom da vida e a Minha Justiça não se faz esperar.’ (Jesus Cristo à Luz de Maria, em 09-02-2016)
‘O espírito do homem está saturado com o mal, tanto que chegou a transgredir os meus Desígnios, através da ciência mal utilizada.’ (Jesus Cristo à Luz de Maria, em 10-07-2016)













